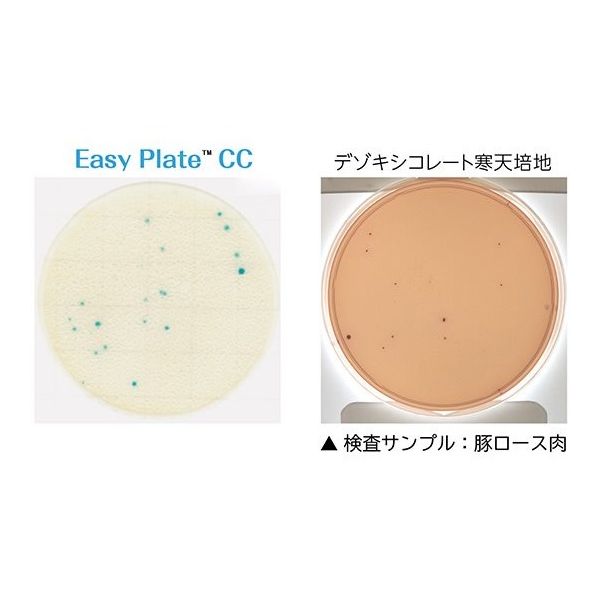

マイストア
変更
お店で受け取る
(送料無料)
配送する
納期目安:
2025.10.15 23:23頃のお届け予定です。
決済方法が、クレジット、代金引換の場合に限ります。その他の決済方法の場合はこちらをご確認ください。
※土・日・祝日の注文の場合や在庫状況によって、商品のお届けにお時間をいただく場合がございます。
アイリスカウファーム Amazon.com: CDI Igniter Ignition Box AM105574 Replacementの詳細情報
Amazon.com: CDI Igniter Ignition Box AM105574 Replacement。Seal for Rocker Arm Cover | 7250374 | Bobcat Company。Amazon.com: AM105574 CDI Box Replacement for John Deere 325。STELLAステラ リール C2500SHG新品未使用箱傷あり(画像参照)袋も希望あればお付けいたしますが、汚れがあります(画像参照)のでご了承ください。。IXC(イクスシー)LOTUS 4drawerロータス 4段ドロアー。お取り置き不可常識の範囲内でお値下げ交渉可その他ご質問コメント欄にお願い致します。釣り用スピニングリール多数セット
ベストセラーランキングです
近くの売り場の商品
カスタマーレビュー
オススメ度 4.1点
現在、4011件のレビューが投稿されています。